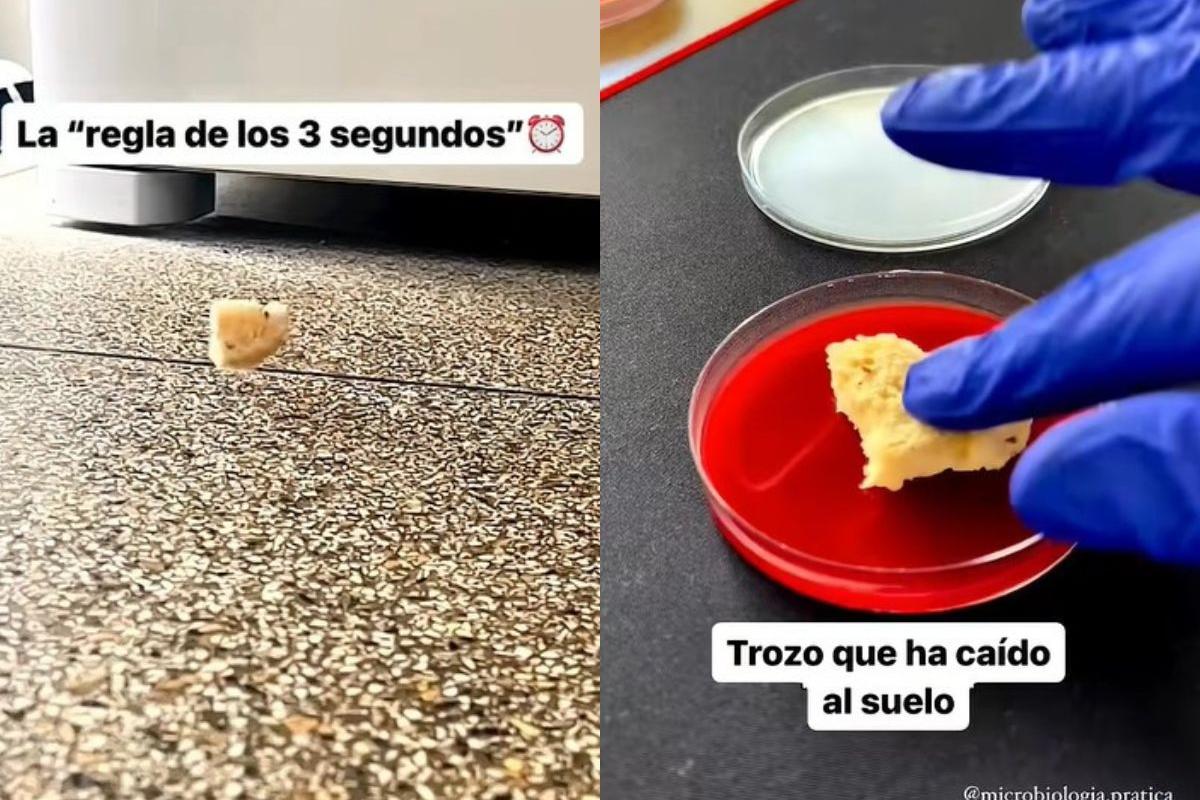

Una científica pone a prueba la 'regla de los 3 segundos': un alimento cae al suelo, lo recoge rápido y lo somete a examen
El resultado es contundente,
Quien más y quien menos, casi todo el mundo ha escuchado alguna vez hablar de la llamada 'regla de los tres segundos', según la cual si un alimento cae al suelo pero lo recoges rápidamente te lo puedes comer sin riesgo porque no le ha dado tiempo a contaminarse con bacterias.
La usuaria de TikTok @ladyscience, doctora en Biomedicina, ha puesto a prueba esa teoría con un resultado claro y demoledor. "Vamos a comprobar si la regla de los tres segundos es un mito o tiene algo de realidad. Es decir, si un alimento cae al suelo y lo cogemos antes de que pasen tres segundos, ¿se ha contaminado realmente?", explica.
Para comprobarlo, ha cogido el alimento que ha estado en contacto con el suelo y lo ha colocado sobre una placa petri y ha hecho lo mismo con el mismo trozo de alimento pero que no ha caído al suelo.
"Después de dejarlos incubando a 37 grados podemos observar que el que ha caído forma gran cantidad de colonias bacterianas, mientras que el que no ha caído al suelo apenas contiene contaminación bacteriana. Ahora ya sabes que lo que cae al suelo no se come", concluye.
En las reacciones, una persona subraya: "Exponernos en cierta media a bacterias hace que nuestro organismo se haga resistente a ellas. Mantenerse en una burbuja nos debilita, eso es la adaptación al medio. Tanto cuesta entenderlo".
Otros bromean: "Se sopla y ya está Como se a echo toda la vida".















